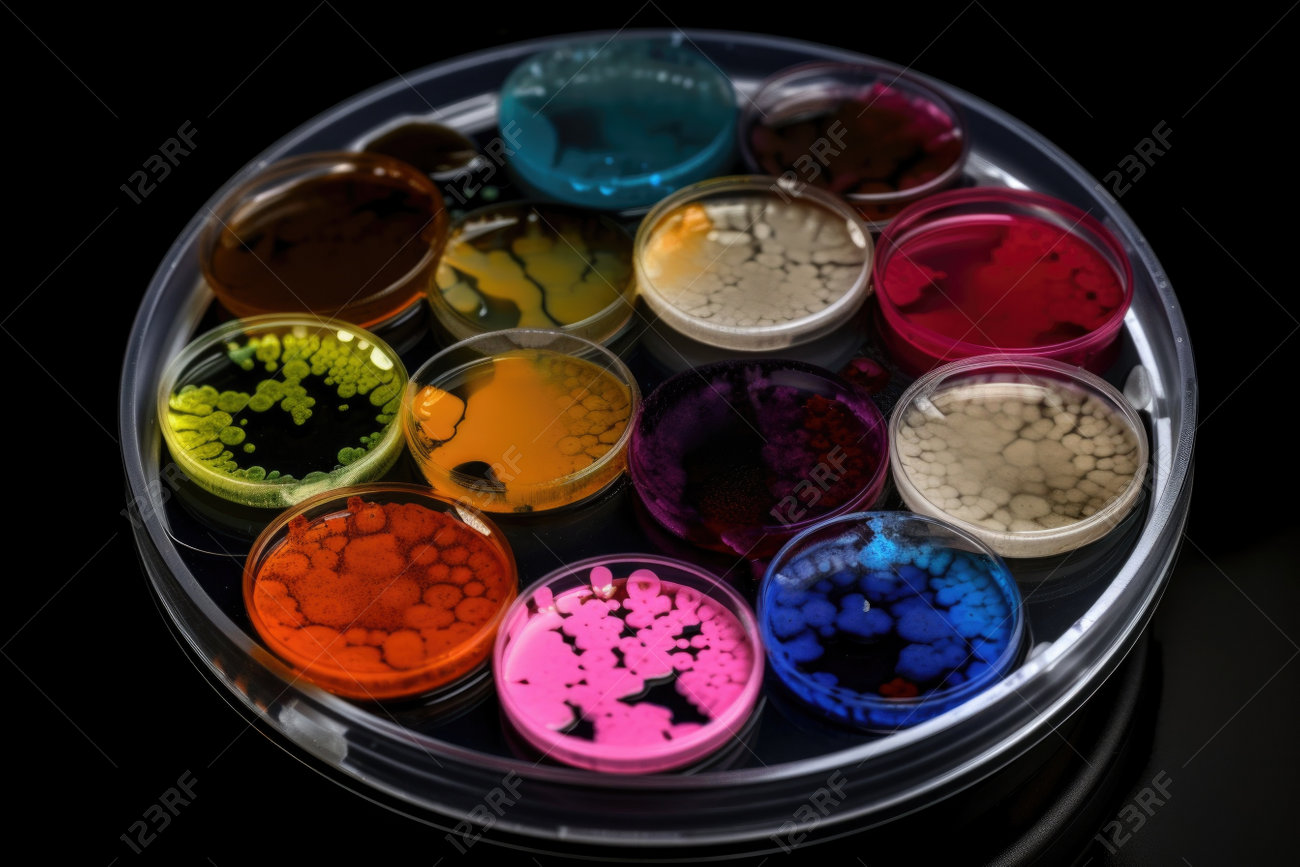
etiam-dictum-ipsum-a-felis

Download
Close
Автор:
id:
Ключевые слова:
ai, array, bacteria, colony, color, culture, experiment, generative, generative ai, growth, laboratory, microbes, microbiology, petri dish, research, science, strain,





